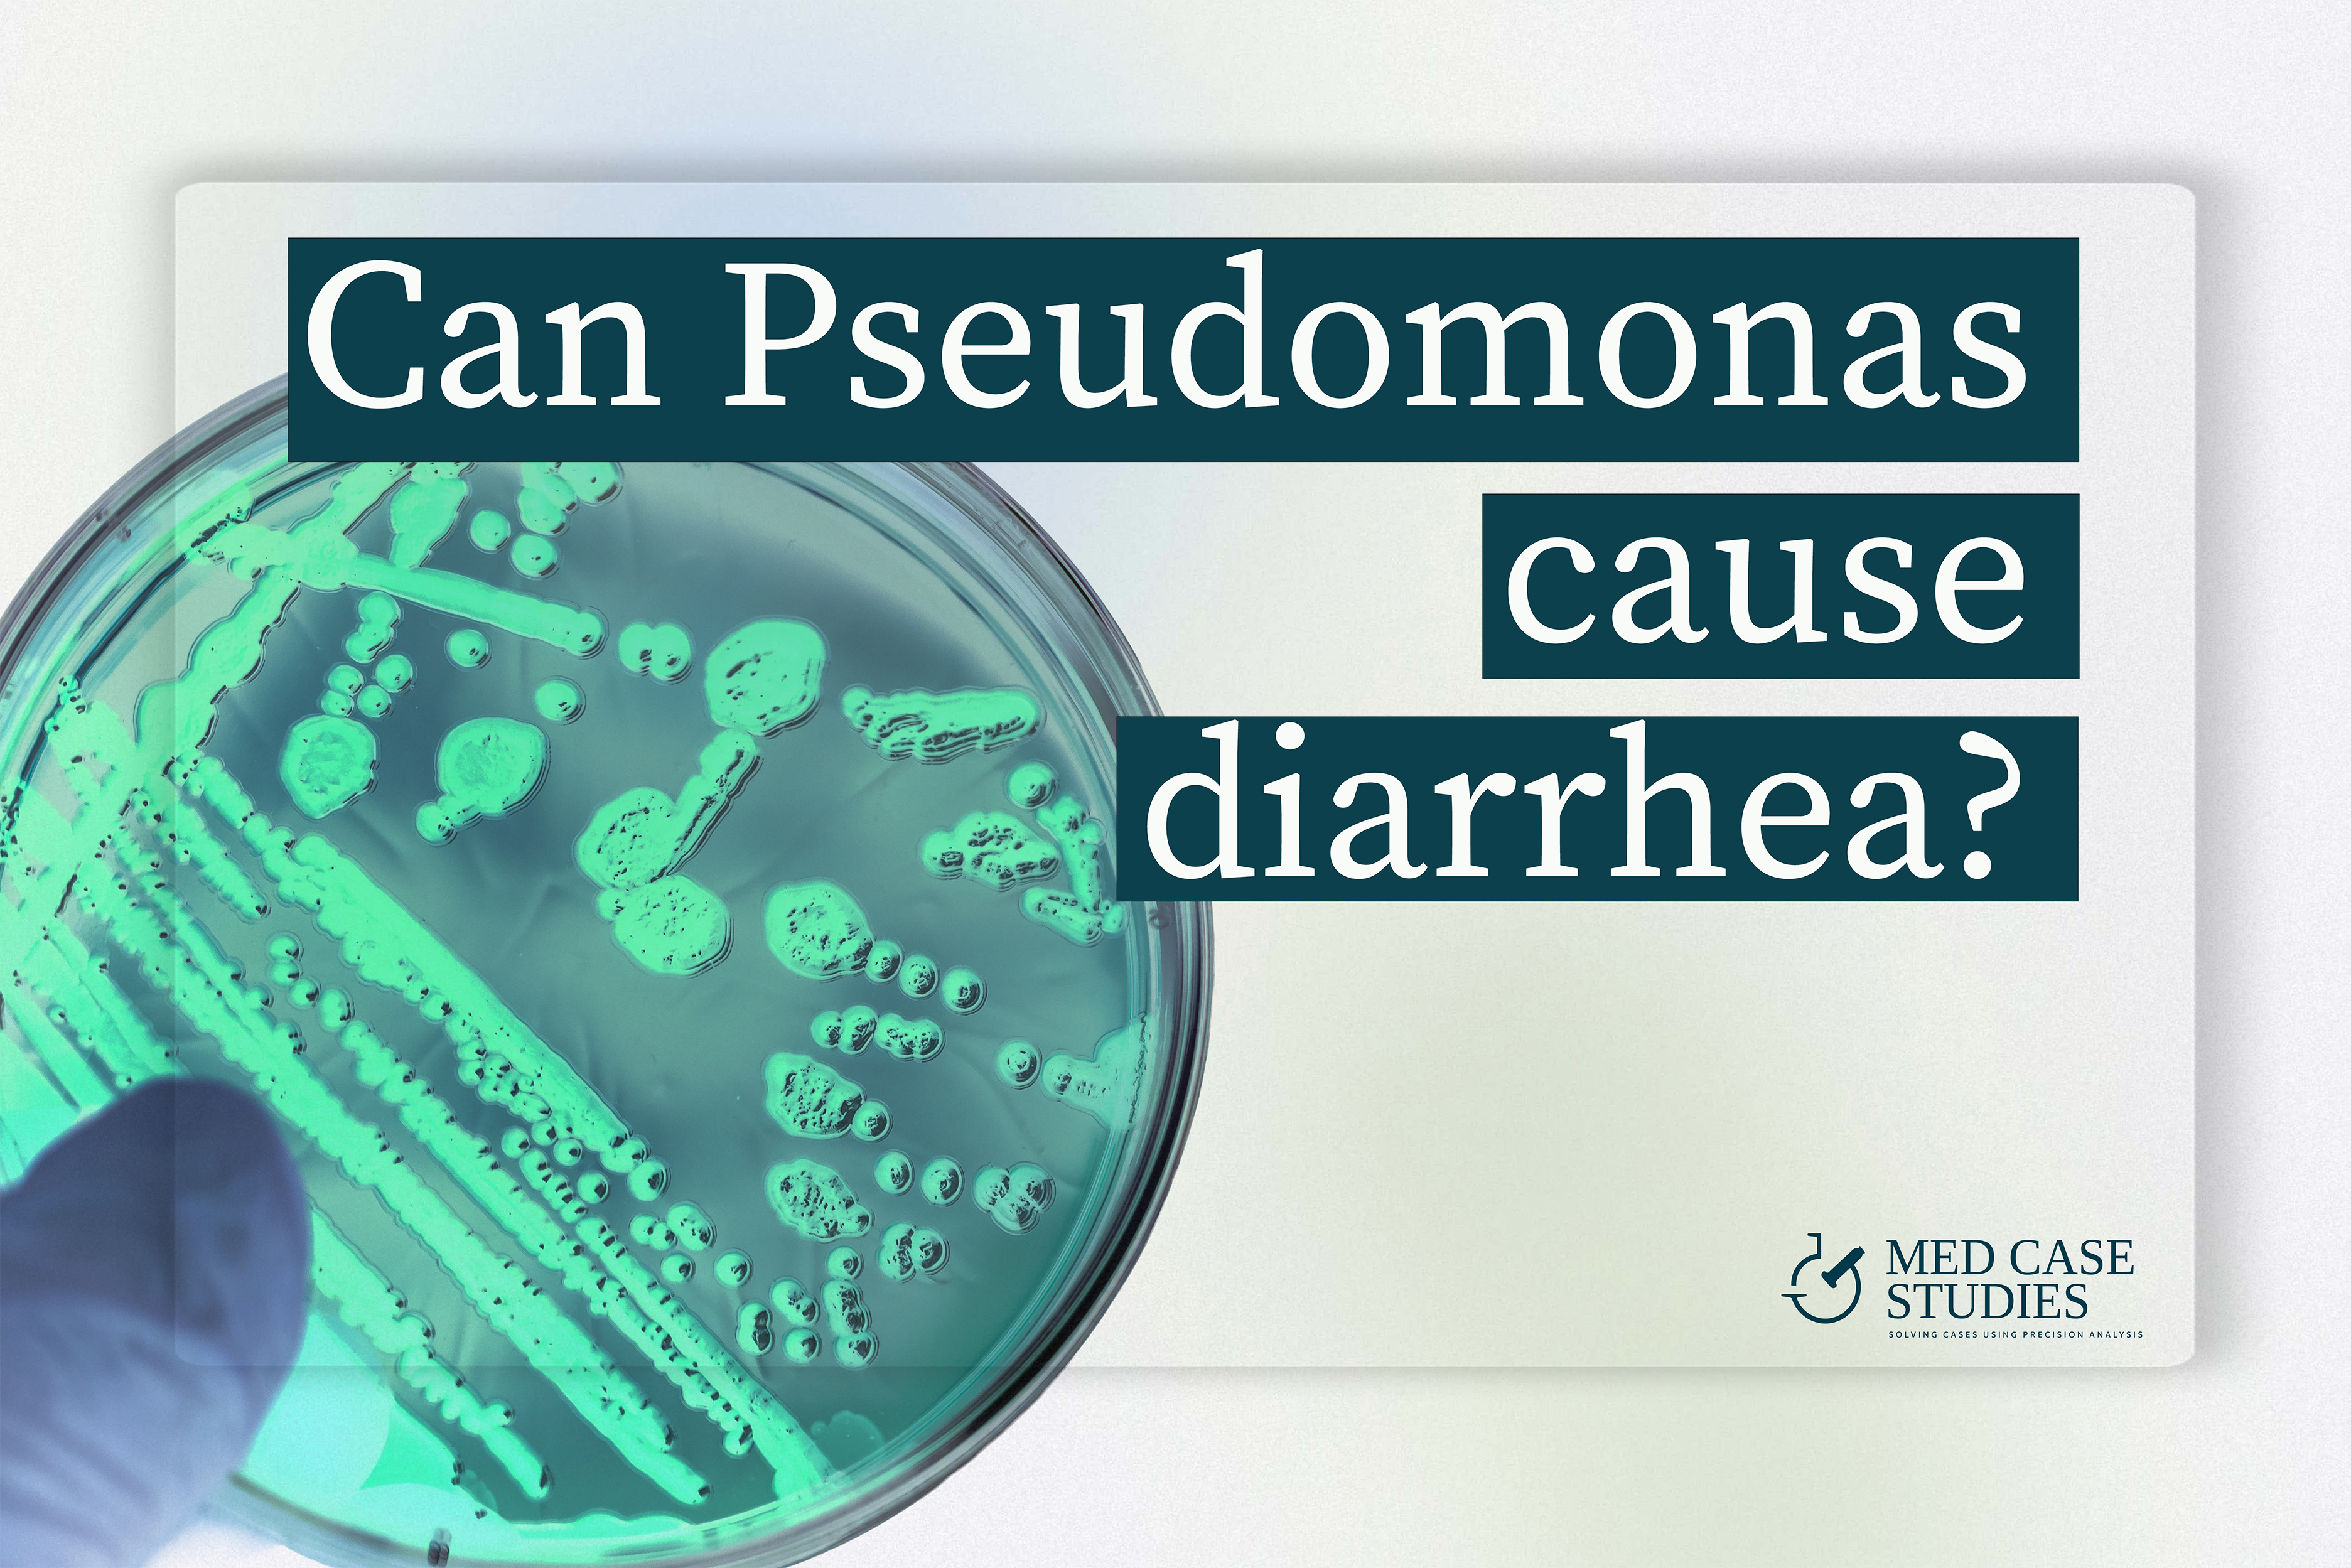
Can Pseudomonas cause diarrhea? Petri dish with teal bacterial colonies and headline on white board, Med Case Studies branding.

Can Pseudomonas cause diarrhea?
Definitively yes. In the gastrointestinal tract this gram-negative acute pathogen can cause infectious diarrhea and antibiotic-associated diarrhea, often in hospitalized or immunocompromised adults but also in community cases. Elastase and other exoproteins disrupt barrier defenses, and a stool test with culture or PCR confirms the organism
How pseudomonas aeruginosa bacteria trigger diarrhea
-
Pseudomonas aeruginosa as a cause of infectious diarrhea is documented in adults in a many cases, often emerging after broad antibiotics as a potential cause of antibiotic-associated diarrhea.
-
Hospital plumbing can seed nosocomial clusters, with documented hospital water outbreaks during post-hospitalization recovery windows.
-
Mechanistically, elastase disrupts epithelial barrier and exoproteins loosen tight junctions, raising permeability and fueling watery stools with abdominal pain.
-
In my clinical experience, over 20% of IBS patients show P. aeruginosa on PCR stool testing during and after flares, as summarized in our practice note on Pseudomonas levels.
-
Differential should include Clostridium difficile toxin positivity. Both follow antibiotic exposure, but management depends on organism and antimicrobial susceptibility.

Dedicated chapter on Pseudomonas-linked diarrhea
Testing, diet levers, and treatment conversations
Clear guidance on stool test selection, antibiotic-associated diarrhea patterns, and case examples that were successfully treated with susceptibility-guided care.
Get the IBSyncrasy bookStool test: culture, PCR, susceptibility
-
A stool test with stool culture confirms bacteria identity and guides an antimicrobial choice; ciprofloxacin has successfully treated selected isolates in culture-guided antipseudomonal therapy.
-
PCR panels can detect pseudomonas aeruginosa as a cause when routine pathogens are negative, clarifying an acute pathogen behind antibiotic-associated diarrhea.
-
Co-colonization from a urinary tract infection site or devices appears in nosocomial settings where flora defenses are reduced.
-
Consider risk factor clusters: recent antibiotic exposure, ICU stay, devices, and enterocolitis during periods of immunocompromise in the gastrointestinal tract.
Mechanisms in the gastrointestinal tract — from stool to enterocolitis
LasB elastase increases permeability and undermines barrier tone, predisposing to infectious diarrhea and urgency.
Secreted exoproducts amplify leakiness and inflammation, a frequent trigger for abdominal pain .
Biofilm biology increases tolerance to drugs and delays clearance in antibiotic-associated diarrhea during recovery.
After antibiotics, flora defenses drop, letting this gram-negative organism expand and drive symptoms.
Reports describe enterocolitis with small-bowel involvement, not just colonic disease, especially after ICU care.
Carbohydrate excess raises gas and bloating alongside diarrhea during recovery from infectious events.
Risk factors linked to stool overgrowth
Recent broad-spectrum antibiotic exposure and ICU devices in nosocomial care.
Chronic antibiotic use or prior bacterial or viral gastroenteritis.
Underlying disease, prior enterocolitis, or periods of immunocompromise.
Community cases occur, particularly after recent antimicrobials and travel.
First line recommendations
Complete gluten free diet to reduce antigenicity due to the elastase activity.
Use of potent antimicrobial blend for at least 3 months to ensure both small and large intestine eradication.
Daily fasting to enhance biofilm susceptibility.
Reduce intake of free sugars and simple carbohydrates to ensure less fermentation and symptomatology.
Takeaway
Pseudomonas aeruginosa can cause infectious diarrhea and is a potential cause of antibiotic-associated diarrhea. Prior antibiotics, fragile microbiome diversity, underlying metabolic disease and exposure to hospital environment are main risk factors.

Chapter on Pseudomonas-linked diarrhea
Testing, diet levers, and treatment conversations
Clear guidance on stool test selection, antibiotic-associated diarrhea patterns, and case examples that were successfully treated with susceptibility-guided care.
Get the IBSyncrasy book
With a background in Chemistry and Biochemistry from the National and Kapodistrian University of Athens, Theodoros brings a wealth of knowledge in functional medicine and advanced treatments to his role. He possesses exceptional skills in analysis, pattern recognition, diagnostic translation, and storytelling. He is also FMU certified in Functional Medicine and has received training in advanced treatments from the Saisei Mirai Clinic in Japan.


